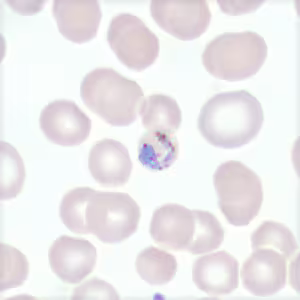
Case 443
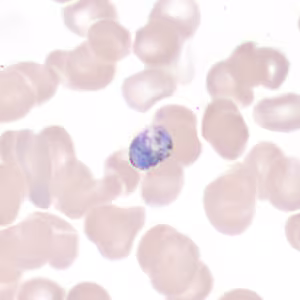
Case 443
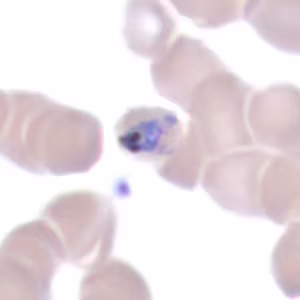
Case 443
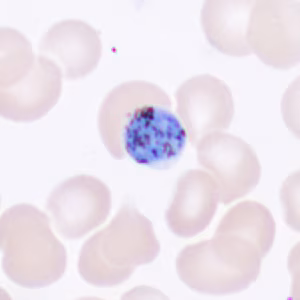
Case 443

Case #443 – May, 2017
A 7-year-old female who had recently moved from the Democratic Republic of Congo to the US was treated for mild, non-immune hemolytic anemia and appeared to be in stable condition. Blood smears were made and stained with Wright-Giemsa at the time of her evaluation. Figures A – K show what was observed. What is your diagnosis? Based on what criteria? What additional tests, if any, should be performed for this case?

Figure A

Figure B

Figure C
Figure D
Figure E

Figure F

Figure G

Figure H
Figure I

Figure J
Figure K
Images presented in the dpdx case studies are from specimens submitted for diagnosis or archiving. On rare occasions, clinical histories given may be partly fictitious.
DPDx is an educational resource designed for health professionals and laboratory scientists. For an overview including prevention, control, and treatment visit www.cdc.gov/parasites/.
